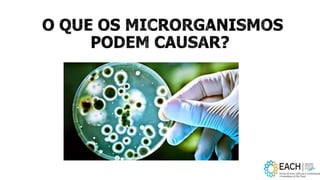

O documento aborda a higiene dos alimentos, destacando a importância do controle de perigos como microrganismos e substâncias tóxicas durante a manipulação e preparo. Enfatiza a necessidade de boas práticas em todas as etapas, desde a recepção até o armazenamento e o preparo dos alimentos, para garantir a segurança alimentar e a saúde do consumidor. Além disso, menciona legislações e medidas a serem seguidas para o adequado manuseio e controle de qualidade dos alimentos.